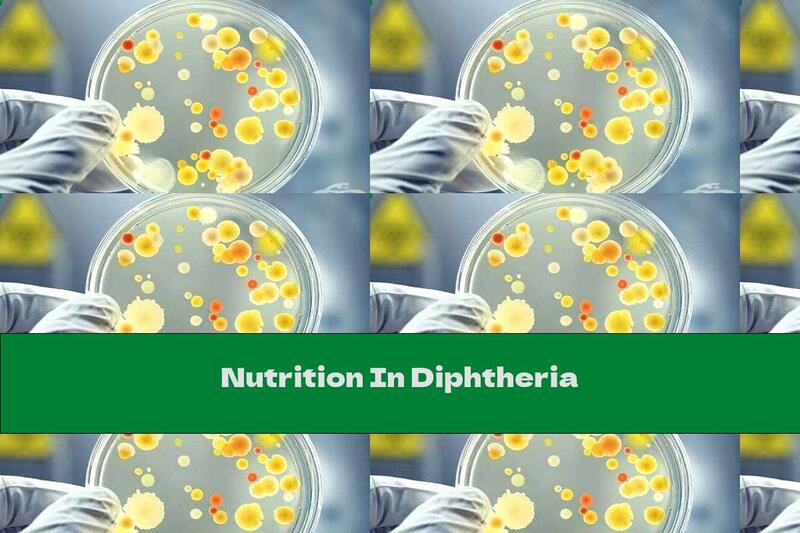
Nutrition In Diphtheria

About |
Privacy |
Marketing |
Cookies |
Contact us
All rights reserved © ThisNutrition 2018-2026
Medical Disclaimer: All content on this Web site, including medical opinion and any
other health-related information, is for informational purposes only and should not be considered to be
a specific diagnosis or treatment plan for any individual situation. Use of this site and the
information contained herein does not create a doctor-patient relationship. Always seek the direct
advice of your own doctor in connection with any questions or issues you may have regarding your own
health or the health of others.
Affiliate Disclosure: Please note that each post may contain affiliate and/or
referral links, in which I receive a very small commission for referring readers to these companies.